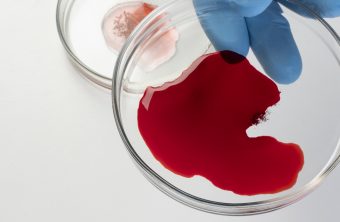

Administración y Gestión, Otras Áreas, Servicios Socioculturales a la Comunidad
499.00 € El precio original era: 499.00 €.339.00 €El precio actual es: 339.00 €.
Curso Atención al Cliente, Consumidor o Usuario
0 out of 5
Cursos de Educación, Cursos de Sanidad, Otras Áreas
499.00 € El precio original era: 499.00 €.260.00 €El precio actual es: 260.00 €.
Curso Ayudante de Cocina en Colectividades (Hospitales-Residencias-Colegios-Comedores Colectivos)
5.00 out of 5
Comercio y Marketing, Otras Áreas
560.00 € El precio original era: 560.00 €.360.00 €El precio actual es: 360.00 €.
Curso Organización y Gestión de Almacenes COML0309
0 out of 5
Cursos de Educación, Cursos de Psicología, Otras Áreas, Servicios Sociales/intervención social, Servicios Socioculturales a la Comunidad
499.00 € El precio original era: 499.00 €.240.00 €El precio actual es: 240.00 €.
Curso Técnico Profesional en Mediación Intercultural en el Ámbito Social
0 out of 5
Administración y Gestión, Otras Áreas
490.00 € El precio original era: 490.00 €.300.00 €El precio actual es: 300.00 €.
Curso Administración y Gestión de Comunidades
0 out of 5
Cursos de Sanidad, Otras Áreas
499.00 € El precio original era: 499.00 €.300.00 €El precio actual es: 300.00 €.
Curso Auxiliar de Clínica de Fisioterapia
0 out of 5
Cursos Celador Sanitario, Cursos de Sanidad, Otras Áreas
499.00 € El precio original era: 499.00 €.260.00 €El precio actual es: 260.00 €.
Curso de Teleemergencias
0 out of 5
Cursos de Sanidad, Otras Áreas
499.00 € El precio original era: 499.00 €.260.00 €El precio actual es: 260.00 €.
Curso en Hematología y Hemoterapia
0 out of 5
Hostelería Y Turismo, Otras Áreas
499.00 € El precio original era: 499.00 €.280.00 €El precio actual es: 280.00 €.
Curso Especialista en Dirección y Gestión de Alojamientos Turísticos Rurales
0 out of 5
Comercio y Marketing, Cursos de Educación, Otras Áreas
499.00 € El precio original era: 499.00 €.260.00 €El precio actual es: 260.00 €.
Curso Experto en Coaching
0 out of 5
Cursos de Educación, Otras Áreas
499.00 € El precio original era: 499.00 €.260.00 €El precio actual es: 260.00 €.
Curso Experto en Dirección de Centros Educativos
0 out of 5
Administración y Gestión, Hostelería Y Turismo, Otras Áreas
499.00 € El precio original era: 499.00 €.260.00 €El precio actual es: 260.00 €.
Curso Gobernanta de Hotel
0 out of 5